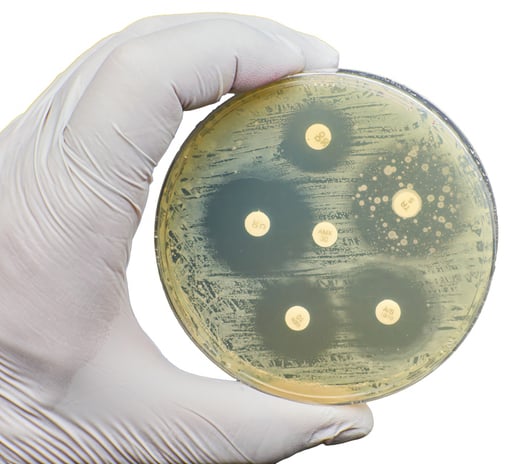

Punto di svolta per il trattamento della gonorrea resistente agli antibiotici. Due nuove molecole sono pronte ad entrare ufficialmente nell'armamentario per combattere una delle più diffuse infezioni a trasmissione sessuale: gepotidacin, appena approvata dalla Food and Drug Administration (FDA) statunitense e zoliflodacin, i cui risultati sull'efficacia sono stati da poco pubblicati su The Lancet. Un'ottima notizia dopo decenni di sostanziale stallo e progressiva perdita di efficacia per gli antibiotici oggi disponibili.
COS’È LA GONORREA?
La gonorrea è un’infezione sessualmente trasmessa causata dal batterio Neisseria gonorrhoeae. A livello globale è la seconda infezione batterica sessualmente trasmessa più diffusa, subito dopo la clamidia. Si trasmette attraverso rapporti vaginali, anali e orali e può colpire genitali, retto e faringe. Uno degli aspetti più insidiosi è la frequente assenza di sintomi: oltre il 50% delle donne e circa il 20% degli uomini infetti non avverte disturbi evidenti. Questo favorisce la diffusione silenziosa dell’infezione e ne ritarda la diagnosi.
QUALI SONO GLI EFFETTI DELL'INFEZIONE?
In gravidanza, la trasmissione al neonato può avvenire durante il parto e causare una congiuntivite neonatale, oggi rara nei Paesi industrializzati grazie alla profilassi antibiotica routinaria alla nascita. Nelle donne può risalire al tratto riproduttivo superiore e causare malattia infiammatoria pelvica, con dolore cronico e infertilità. Negli uomini può determinare epididimite, un’infiammazione dolorosa che, nei casi più gravi, può compromettere la fertilità. In entrambi i sessi, la presenza dell’infezione aumenta il rischio di acquisire o trasmettere l’HIV.
COME SI CURA?
La gonorrea, essendo un’infezione batterica, può essere curata con antibiotici. Il problema è che negli ultimi anni Neisseria gonorrhoeae ha sviluppato resistenze verso gran parte dei farmaci utilizzati, rendendo le terapie sempre meno efficaci. Proprio per questo, quando possibile, la scelta dell’antibiotico dovrebbe basarsi sull’antibiogramma, così da individuare il trattamento più efficace.
Le linee guida attuali indicano come terapia di riferimento l’uso di ceftriaxone -o in alternativa cefixima- spesso in associazione con azitromicina. Una strategia che, pur restando efficace nella maggior parte dei casi, poggia su un numero sempre più limitato di opzioni, aumentando il rischio di nuove resistenze.
QUANDO GLI ANTIBIOTICI PERDONO EFFICACIA
A complicare il quadro delle resistenze è l'utilizzo degli antibiotici a scopo di profilassi. Negli ultimi anni si è diffusa la doxy PEP, l’assunzione di doxiciclina dopo un rapporto sessuale non protetto, per ridurre il rischio di alcune infezioni sessualmente trasmesse. La strategia ha dimostrato di ridurre in modo significativo clamidia e sifilide, ma i dati più recenti mostrano un rovescio della medaglia. Uno studio pubblicato sul New England Journal of Medicine, come raccontato in questo nostro approfondimento, ha evidenziato un rapido aumento delle resistenze nella gonorrea.
DUE NUOVI ANTIBIOTICI EFFICACI
Ma dopo anni di sostanziale stallo, finalmente una buona notizia sul fronte antibiotici per la gonorrea. Dal prossimo futuro si potrà contare su due nuove molecole efficaci. La prima è gepotidacin, un antibiotico appena approvato dall'FDA. Si tratta di una nuova classe di farmaci, somministrabile per via orale, che agisce interferendo con i meccanismi di replicazione del batterio in modo diverso rispetto agli antibiotici tradizionali. Nei trial clinici ha dimostrato un’elevata efficacia nel trattare l’infezione, offrendo un’alternativa concreta alla ceftriaxone, oggi cardine della terapia.
La seconda è zoliflodacin, protagonista di uno studio clinico di fase avanzata pubblicato su The Lancet. Anche in questo caso si tratta di una molecola innovativa, che colpisce la DNA girasi del batterio legandosi a un sito diverso rispetto ai farmaci più utilizzati in passato, riuscendo così ad aggirare molte delle resistenze già diffuse. Nel trial, avviato nel 2019, sono stati trattati 930 pazienti in diversi Paesi, tra cui Thailandia, Sudafrica, Stati Uniti ed Europa. Tra i casi di gonorrea confermata, i tassi di guarigione ottenuti con zoliflodacin sono risultati sovrapponibili a quelli della terapia standard, raggiungendo l’obiettivo principale dello studio.
STABILIRE QUANDO USARLI
Attenzione però a pensare che il problema gonorrea sia risolto con queste nuove terapie. Resta infatti aperto il dibattito su come e quando utilizzarle per evitare che anche queste molecole vengano rapidamente compromesse dall’emergere di nuove resistenze. Senza un uso prudente, una sorveglianza costante e nuove strategie di prevenzione -a partire dallo sviluppo di un vaccino- il rischio è di trovarsi, ancora una volta, punto e a capo.